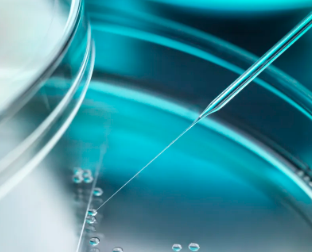
image.png

常州糖尿病干細胞功效如何?治療過程痛苦嗎?
2024-10-22 11:48:51 來源: 小編 咨詢醫(yī)生
糖尿病是一種常見的慢性疾病,近年來,干細胞療法在糖尿病治療領(lǐng)域取得了顯著成果。下面,我們來詳細了解一下常州糖尿病干細胞療法的功效及治療過程。
一、常州糖尿病干細胞功效
1.修復胰島β細胞:干細胞療法能夠分化為胰島β細胞,替代受損的胰島β細胞,恢復胰島素的分泌功能,從而降低血糖。
2.改善胰島素抵抗:干細胞療法可以促進胰島素受體的敏感性,降低胰島素抵抗,使身體更有效地利用胰島素。
3.減少并發(fā)癥:干細胞療法有助于減少糖尿病并發(fā)癥的發(fā)生,如糖尿病足、視網(wǎng)膜病變等。
4.提高免疫力:干細胞療法可以提高患者的免疫力,增強抵抗力,降低感染風險。
5.促進傷口愈合:干細胞療法可以加速傷口愈合,減輕糖尿病患者因血糖升高導致的傷口不易愈合問題。
二、常州糖尿病干細胞治療過程
1.采集干細胞:首先,從患者體內(nèi)采集干細胞,通常采用骨髓、脂肪或血液等來源。
2.干細胞培養(yǎng):將采集到的干細胞在實驗室進行培養(yǎng),增加其數(shù)量和活性。
3.干細胞移植:將培養(yǎng)好的干細胞移植到患者體內(nèi),通過靜脈注射等方式,使干細胞發(fā)揮作用。
4.觀察與調(diào)整:治療過程中,醫(yī)護人員會密切觀察患者的病情變化,根據(jù)需要調(diào)整治療方案。
5.后期康復:治療結(jié)束后,患者需要進行康復訓練,以鞏固治療效果。
三、治療過程痛苦嗎?
糖尿病干細胞治療過程中,患者可能會出現(xiàn)輕微的不適感,如注射部位疼痛、疲勞等。但總體來說,干細胞治療過程的痛苦程度較低,且治療過程中的不適感會逐漸減輕。相較于傳統(tǒng)治療方法,干細胞療法具有較小的創(chuàng)傷和副作用,安全性較高。
總之,常州糖尿病干細胞療法在修復胰島β細胞、改善胰島素抵抗、減少并發(fā)癥等方面具有顯著功效。雖然治療過程可能會有輕微不適,但痛苦程度較低?;颊咴谶M行干細胞治療前,應充分了解相關(guān)信息,并在專業(yè)醫(yī)生的指導下進行治療。
- 2024-10-12干細胞治療與未來治療方法相比哪個更好?前景如何?
- 2024-11-06移植干細胞最新研究進展與突破是什么?
- 2024-11-12翼狀胬肉切除干細胞移植術(shù)是怎么樣的
- 2024-10-15多能干細胞有哪些,不可不知的干細胞分類
- 2024-11-08捐獻干細胞流程是怎樣的?需要注意哪些關(guān)鍵環(huán)節(jié)?
- 2024-11-12自體干細胞移植術(shù)效果如何,有哪些成功案例可參考
- 2024-07-29干細胞醫(yī)療技術(shù),干細胞療法的副作用大嗎
- 2024-09-30上海干細胞移植治療肝硬化效果如何,哪些領(lǐng)域適用
- 2024-09-27艾樂貝拉國際醫(yī)療正規(guī)的嗎
- 2024-09-23淋巴瘤采干細胞過程,淋巴瘤做干細胞移植效果
- 2024-07-29神經(jīng)干細胞激活療法,神經(jīng)干細胞激活療法的作用
- 2024-08-10干細胞治療的原理和方法
- 2024-07-31臍帶間充質(zhì)干細胞費用,臍帶間充質(zhì)干細胞有必要保存嗎
- 2024-07-30脂肪干細胞抗衰,脂肪干細胞抗衰效果好嗎
- 2024-08-27造血干細胞是干什么的,解析其治療潛力和應用
- 2024-08-10多大年齡適合打干細胞針,打干細胞有年齡限制嗎
- 2024-08-30干細胞治療不孕不育有效果嗎多少錢
- 2024-08-04新生兒干細胞儲存費用,新生兒干細胞儲存有必要嗎
